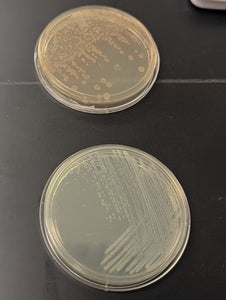

Breakthrough in engineered bacteria is a game-changer for biomedical applications
Left Dr. Jinjin Chen, a researcher in the Lab of Synthetic Biology for Sustainable Development (LSS) Right Dr. Yilan Liu, Professor and Director of the LSS Group
Researchers in the Department of Chemical Engineering have developed a new method for engineering bacteria that can be leveraged to improve biomedical applications such as drug delivery, cancer therapy, anti-inflammatory treatments, and vaccine development.
The international research group, led by Professor Yilan Liu, developed a process that enables bacteria to secrete bacterial membrane vesicles (BMVs). BMVs are nanosized spherical structures naturally released from bacteria. They have significant potential as tools for the development of a variety of therapeutics.
Currently, the adoption of BMVs has been hindered by low production yields under natural conditions. The technique established by Liu resulted in a 140-fold increase in the secretion of BMVs.
"This advancement in bacterial engineering has the potential to be a transformative platform for next-generation vaccines, therapeutics, and nutrient delivery," says Liu. "This new process could profoundly impact global health by making biomedical treatments more efficient, accessible, and affordable."
Top: Engineered bacteria with added nutrients Bottom: Bacteria with no nutrients added
Initial testing demonstrated that engineered bacteria activated the immune system in the gut paving the way for treatments for conditions such as Inflammatory Bowel Disease (IBD) in which patients often have underactive immune systems.
Using fluorescence imaging, the research group tracked the BMVs moving from the stomach to the intestines, with the highest concentration reaching the colon in 24 hours. Providing proof of concept that the engineered bacteria can deliver nutrients or drugs directly to the gut.
Researchers employed two mechanisms to boost BMV secretion. First, a shell protein is inserted into the bacteria’s membrane resulting in a physical drive for vesicle release.
The second step is engineering both hydrophilic (water-attracting) and hydrophobic (water-repelling) BMVs, enabling the modified bacteria to mimic natural cell membranes, enhancing vesicle secretion. This process is easily scalable and cost-effective for therapeutic use.
"This strategy enables us to produce BMVs with unprecedented efficiency without using chemicals," says Liu. "Current methods rely on chemical processes to increase secretion, we've engineered bacteria to optimize their vesicle production naturally, resulting in a cleaner, more sustainable approach."
The next step for the research group is to explore applying this strategy to pathogenic bacteria, like those used in the meningitis vaccine. Utilizing this approach into existing outer membrane vesicle (OMV) systems could increase vaccine productivity and decrease costs.
Liu is investigating the use of BMVs as probiotic supplements to improve nutrient absorption, especially for fat-soluble nutrients such as beta-carotene. The research group is seeking collaborators to further test BMVs for effective probiotic-based nutrition delivery.
The study recently appeared in ACS Nano.